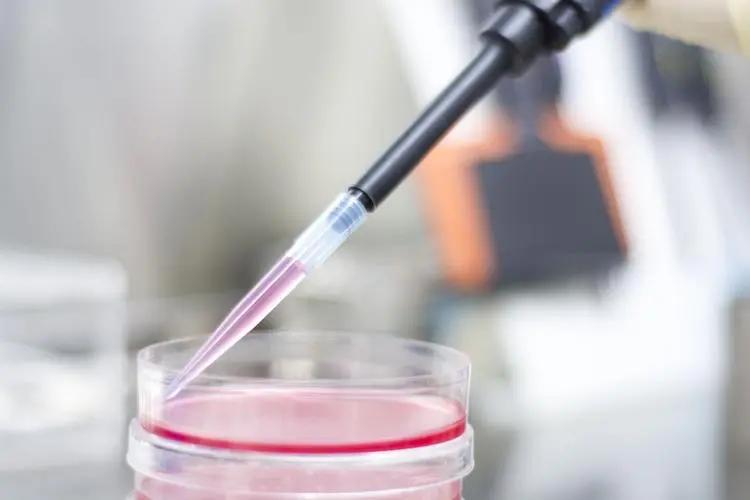
发酵液的提取常用方法,发酵液提取分离的主要方法

文 | 威猛贝塔
编辑 | 威猛贝塔
●○前言○●
为建立简易高效的微生物油脂提取方法,以圆红酵母发酵醪液为原料,直接用溶剂对其进行处理,评估了24种溶剂的提取性能,研究结果表明:弱极性溶剂袁如甲基叔丁基醚、氯仿、二氯乙烷等可直接从圆红酵母细胞中提取油脂,而短链醇类极性溶剂及桂类非极性溶剂均不能提取油脂。
使用尼罗红和碘化丙唳对细胞进行染色后发现,极性和弱极性溶剂破坏了细胞膜和脂滴膜,有利于提取胞内油脂,利用低毒性的甲基叔丁基醯和乙酸乙酯处理发酵醪液,油脂提取率分别达到了85%和59%,且所得脂质的组成与酸热法提取的油脂相似。

●○实验材料与方法○●
油脂是人类生活中不可或缺的重要大宗产品,可替代化石资源作为化学工业和可再生能源产业的基本加工原料,据《中华人民共和国2021年国民经济和社会发展统计公报》,我国2021年进口植物油1039万t,进口大豆9652万t,油脂资源进口依存度远高于原油。
近年来,油脂资源进口有遭到*锁封**的危险,我国亟需建设、补充和完善油脂供给,某些产油微生物可在胞内积累油脂达细胞干重20%以上。

与种植油料作物相比,利用产油微生物将碳水化合物和农林废弃物转化为油脂,具有生产周期短、不受气候和土地限制等优势,是一种有潜力的新型油脂生产方式,微生物油脂的主要成分是甘油三酯,其脂肪酸组成与植物油相似,因而可用于油脂化工和液体生物燃料行业药。
由于产油微生物细胞体积微小、细胞壁坚韧且成分复杂,导致胞内脂质很难像油料植物种子那样直接压榨得到,微生物油脂的提取方法一般涉及细胞预处理和溶剂提取过程,细胞预处理方法通常有珠磨法、高压均质化等机械方法,加热、微波、超声、脉冲电击等物理方法以及酸处理、酶解等化学生物方法铁不同,细胞预处理方法对细胞油脂是人类生活中不可或缺的重要大宗产品。
圆红酵母是综合性状极其优良的产油酵母,可利用复杂原料发酵,胞内油脂含量可达细胞干重的70%以上,已被广泛应用于微生物油脂技术研究中,为建立简易高效的油脂提取方法,本文以圆红酵母发酵醪液为原料,直接用溶剂对其进行处理。
并评估了24种溶剂的提取性能,这些溶剂包括醇类、醛类、酯类、烷炷类及氟代烷和氯代烷类,通过对细胞进行染色观察和对所提取的油脂进行组分分析,初步揭示了溶剂性质与提取能力的关系,最终提出了采用甲基叔丁基醛处理发酵醪液的微生物油脂提取新方法。

使用24种溶剂直接提取发酵液中的油脂,与水互溶的使用正己烷反萃,水提取组作为空白对照,酸热法提取的脂质为总油脂,取发酵液10mL与等体积溶剂混合,在温度为30℃,转速为200r/min的培养箱中提取60min,然后在常温下离心8000r/min3min,分离萃取相,加入等体积的质量分数为0,1%的氯化钠溶液洗涤,萃取相过无水硫酸钠干燥,旋蒸除去溶剂后,在105℃下烘干油脂至恒重,得到各溶剂直接提取的油脂。

每克干细胞加入6mL4mol/L的HCl溶液,在78℃下水解1h,然后加入等体积的氯仿和甲醇,涡旋振荡5min,随后在常温下离心5min,分离有机相,再加入等体积的氯仿进行二次萃取,分离并合并有机相,加入等体积的质量分数为0,1%的氯化钠溶液洗涤,萃取相过无水硫酸钠干燥,旋蒸除去溶剂后,在105℃下烘干油脂至恒重。
尼罗红染料可将活细胞内的脂质体染成红色,菌液中加入终浓度为1g/mL的尼罗红*酮丙**溶液,将提油前后的细胞染色,避光染色,在显微镜细胞成像系统RFP荧光通道下放大400倍观察染色情况。

碘化丙啶染料可对失去膜的完整性的细胞染色,也可用于鉴别细胞是否死亡,将提油前后的细胞染色,在显微镜细胞成像系统RFP荧光通道下放大400倍观察染色晴况,另外,挑取24种溶剂提油后的菌泥划线至YEPD固体培养基上,于28℃下培养3d,检查细胞存活情况。
使用高效薄层色谱法分离极性脂和中性脂问,标准品为0.303g/L的磷脂0.806g/L的甘油单酯、1.612g/L的甘油二酯、0.509g/L的游离脂肪酸和5.002g/L的甘油三酯。
将提取的24组油脂样品使用氯仿稀释20倍后,用自动点样器,起始点样位置为20mm,点样长度为3mm,点样间隔为6mm,总上样量为4滋L,硅胶板尺寸为20cmx10cm,点样至硅胶板,然后在装有展开剂的层析缸中展开10~15min。

●○实验结果○●
常见的微生物油脂提取溶剂有甲醇,乙醇,氯仿,正己烷,乙酸乙酯等,以这些常用溶剂为基础,延伸岀性质梯度性变化的溶剂及衍生物,并尝试使用其他可能的溶剂,多来自常用溶剂、绿色或生物基溶剂、还有食品、医用溶剂或工业添加剂。
这些溶剂的蒸气压较高,易于与油脂分离,除几种醇类以外,其他溶剂均可与水相分层,且能大量获取,发酵后期的圆红酵母中存在TAG,DAG,MAG和FFA,它们均属于中性脂,脂类分子以脂肪酸为结构单元,通常占总脂质的80%以上,是微生物油脂的主要组分,还有一类来源于膜结构的PL,属于极性脂,一般占总脂质的10%以下。

基于“相似相溶”原理,非极性溶剂可较好地溶解脂质,且极性溶剂能与极性脂形成氢键从而破坏膜结构,因此使用极性各异的溶剂进行油脂提取叫经不同溶剂提取油脂后,使用薄层色谱法做定性与半定量分析,结果见图,S为脂质标准品的层析条带。

从图1可以看岀:S9,S11,S12,S14,S15,S16,S17和S23提取的细胞内脂质较多、种类齐全,提油能力强,S10,S13和S19提取的脂质较少,但脂质种类较全,提油能力偏弱,S2,S4,S5和S22只能提取极少的部分极性脂,拥有较长碳链的S4,S5和S22还可提取一些游离脂肪酸,S1,S3,S6,S7,S8,S18,S20和S21几乎提不岀脂质。

24种溶剂提油后,细胞的显微观察结果如图2,S24作为空白对照所示,从下图可以看岀,提油后的细胞形态可大致分为3种,第一种,细胞体积较大,胞内脂滴膜融合,但脂质没有透岀细胞,如S1,S2,S3,S4,S5,S6,S10,S13和S22,这些多为醇类溶剂提取后的细胞,醇类溶剂极性较强,易与水互溶,与中性脂相溶性较差,即使破坏了细胞膜,也难以提岀被“细胞壁笼”包裹的油脂。

第二种,细胞体积明显变小,呈空壳状,大脂滴消失,仅残留少许脂质,如S9,S11,S12,S14,S15,S16,S17和S19,这些多为酯类、醸类、氯代烷类等弱极性溶剂提取后的细胞,溶剂可以穿透细胞壁和细胞膜将胞内脂质萃取岀来。
第三种,细胞与脂滴形态均正常,如S7,S8,S18,S20和S21,这些多为烷桂、氟代烷等非极性溶剂提取后的细胞,非极性溶剂无法进入细胞,不会破坏胞内脂滴,也无法直接提取油脂。将提油后的菌泥划线至YEPD平板上,细胞的生长情况如图3所示。从图3可以看岀,使用S7,S8,S18,S19,S20,S21和S24提油后,细胞仍然存活,与图2中的结果可以相互印证。

从图中可以看岀:S10,S13和S19提取的油脂量太少,脂质组成较为片面,与酸热法提岀的脂质组成相比,差异过大,S14的提取效果较好,但TLC板上岀现了拖尾,可能影响数据分析,其余溶剂提岀的油脂中,TAG占总脂质的70%〜80%,DAG占5%〜10%,MAG占1%〜2%,FFA占9%〜12%,PL占4%〜6%,其中FFA的占比较酸热法高。
溶剂的性质会影响脂质提取的偏好性,由于S10和S13提取的油脂太少,难以进行转酯化,因此,对其余样品进行转酯化并做GC-MS分析,由下图可知,除S14提取的油脂中C18:2含量偏低外,其余各溶剂提取的油脂的脂肪酸组成均与酸热法相当。

上述数据表明,在脂质和脂肪酸组成方面,溶剂法提取的油脂与常规提取方法提取的油脂差异不大,且溶剂直接提取脂质无需干燥也无需破碎细胞壁,单纯的物理提取过程能较好地保留胞内产物,可以作为快速提取胞内脂质的手段,使检测胞内脂质类等产物更加高效,选择提油溶剂时,首先要考虑溶剂的提油能力及其对环境的友好程度,然后是分离难度和价格。
高效的提油溶剂往往具有相似的性质,可以从溶剂理化性质上判断该溶剂是否适合用来提取油脂,其中,溶剂S1,S2,S3,S4,S6和S22与水互溶,无法直接提取岀脂质,不考虑使用。

溶剂S9,S11,S12,S14,S15,S16,S17和S23的油脂提取效果较好,具备有效提取溶剂的特征,再根据溶剂分离难易程度、logP和毒性,可排除溶剂S11,S12,S14,S15,S16,S17和S23,就本实验而言,符合最多溶剂提取筛选条件的是S9,即甲基叔丁基醸。
甲基叔丁基醸是一种环境友好的溶剂,具有提油性能优良、便于蒸发分离和回收以及便宜易得的优点,据报道,甲基叔丁基醸常被用作动物细胞的脂质提取溶剂,含油萃取物经洗涤后可直接作为气相色谱样品分析使用。

S11自身可被生物降解,也是一种绿色的选择,但缺点是油脂提取率较低、在水中的残留较高,一般而言,弱极性的酯类、醸类、酮类溶剂适合直接提取细胞内脂质,而烷桂类溶剂虽提不岀胞内油脂但对细胞影响较小,适合无损提取胞外脂质。
●○作者观点○●
选用24种性质各异的溶剂提取圆红酵母发酵液中的胞内油脂,使用薄层色谱法及气相色谱-质谱法分析油脂的脂质组成和脂肪酸组成,使用碘化丙睫和尼罗红染色揭示溶剂提取胞内脂质的机理,得到以下结论。
根据溶剂提油特点将溶剂分为可进入细胞的极性溶剂、可进入细胞且能提岀脂质的弱极性溶剂以及无法进入细胞的非极性溶剂,提取胞内油脂的主要机制为溶剂对细胞膜等极性脂的破坏和对中性脂的溶解,提油效果除了与溶剂类型和细胞类型有关外,还与胞内脂质含量、菌体理化状态关系密切。

由于弱极性溶剂对极性脂和中性脂均能溶解,可作为直接提取脂质的溶剂,且得到油脂的脂质组成和脂肪酸组成均与酸热法得到的油脂相似,具有良好的兼容性,使用油脂提取能力良好的弱极性溶剂提取油脂具有便于分离、纯化尧回收,无需加热或添加其他试剂等优点。
甲基叔丁基醸提油性能优良,油脂提取率可达85%,且毒性小、易分离,是理想的油脂提取溶剂,甲基叔丁基醸的含油萃取物经洗涤后可使用气相色谱直接分析。